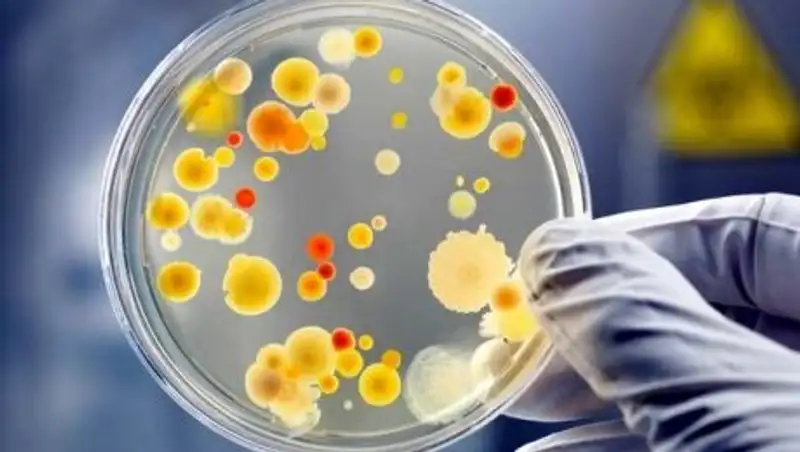
Минздрав: случаев заболевания чумой среди населения и животных в РК не зарегистрировано

Осторожно, опасные заболевания: в мире зарегистрировано 19 случаев чумы
 WomanAdvice.ru
WomanAdvice.ru
Главный санитарный врач Казахстана проинформировал граждан о ситуации в мире с инфекционными заболеваниями, передает корреспондент Zakon.kz.
"Комитет охраны общественного здоровья министерства здравоохранения, учитывая предстоящие зимние каникулы и возможные выезды на отдых за рубеж, информирует, что в ряде стран отмечается неблагополучная ситуация по следующим инфекционным заболеваниям", - сказал председатель комитета охраны общественного здоровья министерства здравоохранения РК Жандарбек Бекшин во время пресс-конференции в Службе центральных коммуникаций.
По его данным, в мире зарегистрировано 19 случаев чумы: по одному в США, Боливии и Перу, 16 в Мадагаскаре.
251 542 случая холеры: 120 в Индии, из которых 13 летальных, 15 случаев в Саудовской Аравии и четыре случая в Канаде, один летальный случай в США.
Сибирская язвой в мире заболело 175 человек, из них три летальных случая. В Индии 30, в Китае - 23 (один летальный), в Кыргызстане - 23 случая, в Грузии - 3 случая.
Лихорадка Эбола: в Конго зарегистрировано 203 случая, из них 120 летальных.
Лихорадка Денге: зарегистрировано 225 329 случаев, из них 276 летальных, в Бразилии - 8900 случаев, Филиппины - 62 632 случая, из них 64 летальных, Малайзия 36 161 случай, 59 летальных, Таиланд - 60 тысяч случаев, 70 летальных, Китай 18 случаев.
"Также в двух странах Европы зарегистрированы завозные случаи Денге, Россия - 59 завозных из Таиланда, Вьетнама, Индонезии, Индии, Бангладеша, Гонконга, Мальдивских островов; в Италии один завозной случай из Таиланда. Дифтерия зарегистрирована в Украине", - добавил он.
Также, по его словам, в странах Европейского региона регистрируется осложнение ситуации по заболеваемости корью, где зарегистрировано более 70 тысяч случаев, из них в Украине более 40 тысяч случаев, Сербии почти 5 тысяч случаев, Франции 2771, Италия 2599, Россия 2327, Таиланд 2149, Грузия 1471, Израиль 1401, Кыргызстан 448 и другие. Зарегистрировано 68 случаев летальных.
По его мнению, рост заболеваемостью корью в Европе ВОЗ связывает с низким охватом вакцинации против кори.
Татьяна Ковалева, Астана